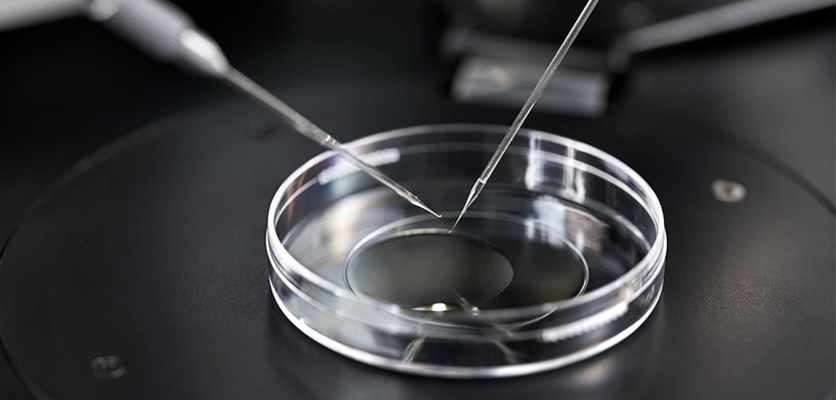

24 July 2024
•4 minute read
Expecting Multiples: Challenges & Solutions of Carrying More than One Baby!
Imagine the moment you discover that within you exists two, three, or even more tiny hearts. “I’m carrying more than one baby!” is a phrase that carries with it a weight of wonder (and complexity!). The prospect of simultaneously nurturing not one, but multiple lives, can be both exciting and, truthfully, a tad intimidating for new mums-to-be. Not to forget, the demands of caring for multiple newborns must also be considered and managed effectively.
Busting common myths about expecting multiples
A twin or multiple pregnancy is a pregnancy with more than one fetus. “It is a common misconception that all twins are identical. In general, all twins can be divided into identical (monozygotic) and non-identical (dizygotic or fraternal) twins,” says Consultant Obstetrician & Gynecologist from Columbia Asia Hospital – Petaling Jaya, Dr. Shrilekha Suriya Narayanan.
Identical twins are formed when a single embryo is fertilized by two sperms and further divides into two embryos, sharing a placenta. On the other hand, nonidentical or fraternal twins occur when two embryos are fertilized by two separate sperms, resulting in two fetuses in their own gestational sacs and with separate placentas.
“It is also often misconceived that mothers carrying twins or more babies are required to eat for three, but this is untrue. Growing two or more babies is hard work, but a healthy weight gain is crucial,” adds Dr. Shrilekha. “For example, a woman having twins should gain about 16 to 20 kg throughout the pregnancy. One should only need an additional 600 healthy calories added to her typical diet, and this can vary from one individual to another.”
Lastly, it is frequently thought that when one is carrying multiple babies, they will need bed rest. In reality, women with multiple babies are encouraged to continue their daily activities as usual, especially when their pregnancy is progressing normally. However, some will require bed rest, especially when they are at risk of premature delivery or other pregnancy-related complications.
What are the chances of getting twins or more?
Several factors can increase the likelihood of having twins. Fertility treatments, such as those involving ovulation-inducing drugs used in invitro fertilization (IVF), can stimulate a woman’s ovaries to release more than one egg. This leads to the possibility of both eggs being fertilized.
Age is another factor. Women over 35 are more likely to release multiple eggs during their reproductive cycle, increasing the chances of twin pregnancies.
Genetic predisposition also plays a role; a family history of twins, particularly on the mother’s side, raises the likelihood of conceiving multiples. Additionally, women who have had previous pregnancies with multiples, such as twins or triplets, have a higher chance of conceiving multiples again.
Multiples on board: The challenges and solution

Being pregnant with more than one baby is an exciting and happy event for a couple. However, there are certain challenges and risks the mother faces when carrying twins or multiples.
“Women expecting twins or more are at a higher risk of developing Gestational Diabetes Mellitus because the increased size or number of placentas can lead to insulin resistance. So, they will need to undergo a sugar test to screen for this condition during pregnancy. Also, they may be more prone to anemia due to the greater nutritional demands, but this can be managed with iron supplements,” explains Dr. Shrilekha.
Other than that, there is also an increased risk of developing Gestational Hypertension, or even worse, pre-eclampsia. If diagnosed with these conditions, the mother will need regular and close follow-up appointments and may require antihypertensive agents to control her blood pressure, or even the need for early delivery if complications arise.
“Those expecting multiples may experience heartburn or acid reflux. To manage this, it is helpful to make a few lifestyle changes, like eating your last meal at least three hours before bedtime, avoiding foods that trigger symptoms, and elevating your head while sleeping. In some cases, your doctor might prescribe antacids to help relieve these symptoms.
“Some mothers might also experience lower back pain or sciatica, which is a pain or tingling that radiates down the leg. To help with this, wearing shoes with good arch support, sitting in chairs that offer good back support, sleeping on your side, and placing a pillow between your knees for extra support can be beneficial,” says Dr. Shrilekha.
A closer look at the complications of multiple pregnancies

Other than the mothers, the unborn babies may also face potential complications. The risk of preterm birth is three times higher in twin pregnancies, but not all will result in early delivery. According to Dr. Shrilekha, premature birth may occur spontaneously or be medically necessary due to conditions such as worsening maternal health, stunted fetal growth, or signs of infection.
Transvaginal ultrasound of the cervical length before 24 weeks gestation is the most effective tool for predicting preterm birth, regardless of other risk factors. The use of vaginal progesterone in women with shortening cervical length in multiple pregnancies has been shown to reduce the risk of preterm birth as well as perinatal mortality.
Other preventive measures include cervical cerclage and an Arabin pessary placement. Cervical cerclage is a surgical procedure where stitches are used to close the cervix during pregnancy to prevent premature birth or miscarriage. An Arabin pessary is a silicone device placed around the cervix to provide support and reduce the risk of preterm labor.
“Multiple pregnancies also have a higher risk of intrauterine growth restriction, where one or more of the babies may weigh less than expected for the particular gestation. This can occur with twins and other multiples because they have less space or because the placenta might not be able to provide enough nourishment for all of them,” says Dr. Shrilekha.
“Another condition to be aware of is twin-to-twin transfusion syndrome, which is a serious complication that can happen with identical twins. This occurs when blood flows unevenly between the twins through their shared placenta. One baby ends up getting too much blood, which strains their cardiovascular system and leads to an excess of amniotic fluid. Meanwhile, the other baby does not get enough blood and has too little amniotic fluid,” explains Dr. Shrilekha. Twins sharing an amniotic sac can also become entangled in their umbilical cords. Because of these risks, it is crucial to closely monitor twins, especially in the third trimester.
This article first appeared in Parenthood, 24 July 2024.
Share:
Was this article helpful?
24 July 2024
•4 minute read
Expecting Multiples: Challenges & Solutions of Carrying More than One Baby!
Learn more about Obstetrics And Gynecology in Columbia Asia
Learn MoreShare:
Was this article helpful?
Health Packages
Elevate your health with tailored health packages at Columbia Asia Hospital. Take charge of your health journey today.

